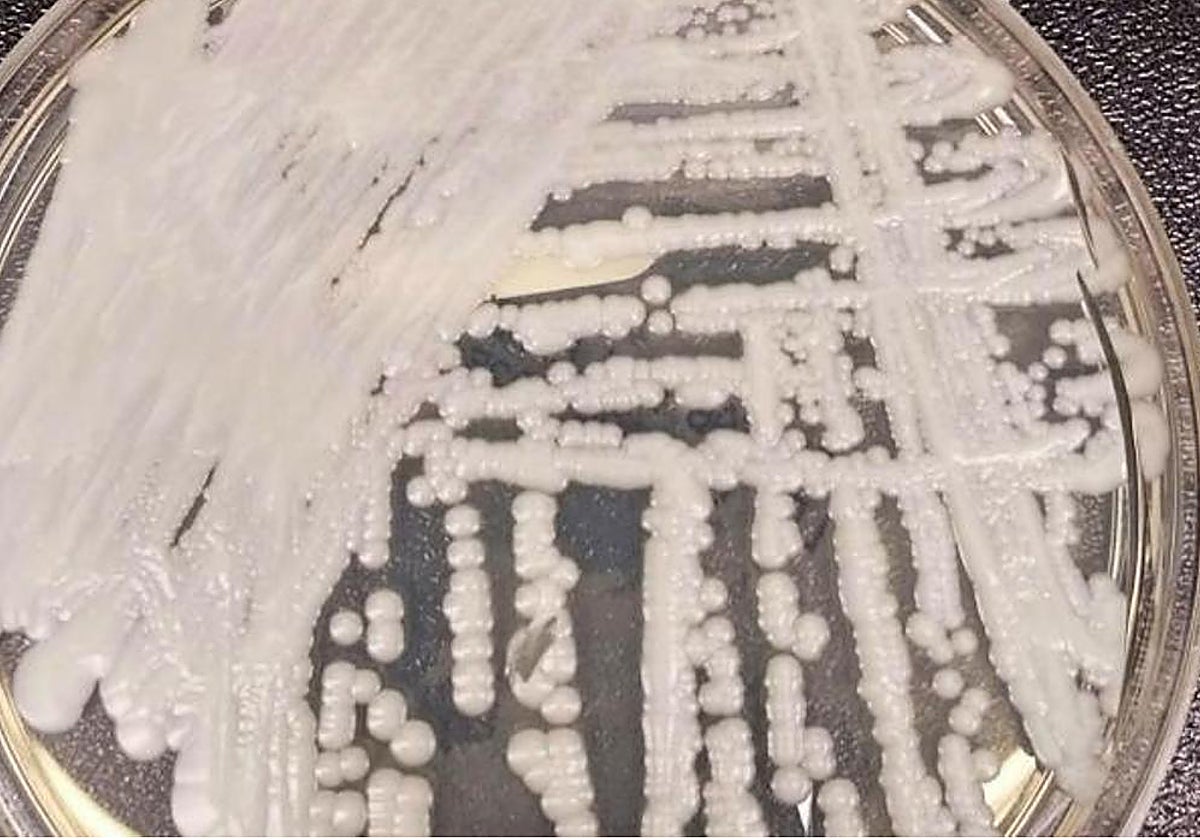
Una cepa de Candida auris cultivada en una placa de Petri en los Centros para el Control y la Prevención de Enfermedades (CDC

La lista negra de los hongos que nos enferman: ¿por qué son tan peligrosos?
Los casos mudiales de enfermedades fúngicas invasivas se están incrementando
Antonio G. Pisabarro/Denisse Patricia Rivera de la Torre
Las enfermedades infecciosas aún están entre las principales causas de mortalidad; principalmente en países de bajos ingresos, donde representan seis de las diez primeras causas de mortalidad. No obstante, su incidencia global ha ido disminuyendo durante los últimos años.
Y aunque esto último es ... cierto para las enfermedades producidas por bacterias y virus (dejando de lado la situación excepcional de la pandemia de covid-19), lamentablemente no ocurre con las enfermedades fúngicas invasivas (EFI). Los casos mudiales de EFI se están incrementando, especialmente entre las personas con algún tipo de deficiencia inmunitaria.
La aparición de nuevos patógenos, el aumento de las resistencias y la falta de fármacos antifúngicos han hecho que las EFI se conviertan en candidatas a causar crisis sanitarias silenciosas en el futuro.
La amenaza está en el aire
Los hongos forman un grupo de microorganismos altamente peligrosos como agentes patógenos por las siguientes razones.
Estructuralmente, son más similares a los animales que las bacterias o los virus. Por eso resulta tan difícil encontrar balas mágicas antifúngicas que causen efectos secundarios limitados sobre los pacientes.
Pueden diseminarse a través de esporas microscópicas suspendidas en el aire: se han detectado hasta 50.000 por metro cúbico. Si tenemos en cuenta que respiramos en torno a 8.000 litros de aire al día, podríamos entrar en contacto con unos 50 millones de esporas de hongos cada jornada. Y eso sólo considerando las vías aéreas.
Aunque nuestras barreras inmunes nos protegen de posibles infecciones por hongos, el aumento de personas con las defensas debilitadas por diversas causas hace que la población susceptible a infecciones fúngicas sea cada vez mayor.
Lista de patógenos fúngicos prioritarios de la OMS
Para abordar la amenaza de los hongos causantes de EFI, la organización Mundial de la Salud (OMS) ha publicado recientemente la Lista de Patógenos Fúngicos Prioritarios (LHPP), elaborada mediante un proceso cooperativo internacional de varios años.
Esta lista completa un esfuerzo anterior destinado a la elaboración de la Lista de Bacterias Patógenas Prioritarias, hecha pública en 2017.
La LHPP se ha centrado en patógenos causantes de infecciones invasivas, agudas o subagudas, en las que se han detectado amenazas para la salud debidas al aumento de las resistencias a fármacos antifúngicos o a otros tipos de tratamientos.
El propósito de la OMS al elaborar la LHPP es enfocar los esfuerzos de diagnóstico y vigilancia de estos patógenos, estimular la investigación, el desarrollo y la innovación en el tratamiento de las enfermedades que causan y estimular el diseño de medidas de intervención de salud pública.
La LHPP está dividida en tres apartados:
Grupo crítico. Aquí están los patógenos más dañinos: Cryptococcus neoformans, Candida auris, Aspergillus fumigatus y C. albicans.
Grupo de alta prioridad. En esta categoría entran C. glabrata, Histoplasma spp., los agentes causantes de las enfermedades de la piel llamadas eumicetomas, Mucorales, Fusarium spp., C. tropicalis y C. parapsilosis.
Grupo de prioridad media. Es el de Scedosporium spp., Lomentotospora prolificans, Coccidioides spp., C. krusei, Crypococcus gattii, Talaromyces marneffei, Pneumocystis jirovecii y Paracoccidioides .
Causantes de epidemias, oportunistas, emergentes...
Algunos de estos microorganismos pueden dar lugar a brotes epidémicos, como ocurre con Histoplasma o C. auris. Otros son oportunistas que infectan a grupos de riesgo especial (pacientes con infección por VIH, por ejemplo). Aunque hay tratamientos disponibles, estos no evitan una alta mortalidad y no son asequibles en países con bajos ingresos.
Además, ciertos hongos pueden considerarse patógenos emergentes. Es el caso de la citada C. auris, que es resistente a la mayoría de los antifúngicos, a las altas temperaturas y a los desinfectantes más comunes.
Y por último, hay patógenos distribuidos globalmente, como Fusarium, que presentan resistencia innata a la mayoría de los fungicidas disponibles.
La elaboración de la lista ha puesto de manifiesto que el aumento de la amenaza causada por las EFI se debe al incremento de la resistencia a antifúngicos, las limitaciones del diagnóstico y la falta de acceso a medidas de tratamiento, especialmente en países de ingresos más bajos.
El problema de la resistencia a antifúngicos se puede encuadrar dentro del aumento generalizado de las resistencias a antibióticos a nivel mundial.
Además, en el caso de los antifúngicos, la situación se agrava por dos razones. Por un lado, el número de familias de este tipo de fármacos es muy limitado. Sólo hay cuatro tipos de los llamados sistémicos (azoles, equinocandinas, pirimidinas y polienos) cuya administración requiere una experiencia y una vigilancia farmacológica a las interacciones que no siempre es posible.
Por otra parte, el uso masivo de azoles en agricultura facilita la aparición de resistencias que inhabilitan el uso de estos compuestos.
Objetivo: mejorar el tratamiento y el diagnóstico
Urge, por tanto, investigar más en el desarrollo de nuevos compuestos quimioterapéuticos para tratar las EFI y regular su uso en otras aplicaciones distintas de la práctica clínica. Solo así se evitará la aparición de resistencias, especialmente en las especies de amplia distribución o capaces de causar brotes epidémicos.
Adicionalmente, las limitaciones del diagnóstico de las EFI constituyen otro factor relevante a la hora de abordar el problema. A menudo, la sintomatología de estas infecciones es atípica, los test de diagnóstico tienen poca sensibilidad o especificidad y el tiempo requerido para realizar un diagnóstico es demasiado largo, lo que impide un tratamiento efectivo en las etapas iniciales de la infección.
De nuevo, como en el caso de los antifúngicos, es necesario impulsar la investigación para el desarrollo de nuevos sistemas de diagnóstico más rápidos y seguros y un esfuerzo de formación.
Los hongos patógenos causantes de infecciones sistémicas son un peligro y causa de preocupación creciente en salud pública y en entornos hospitalarios no solo en países de bajos recursos económicos, sino en todo el mundo. La Lista de Hongos Patógenos Prioritarios es una llamada de atención para organizar las medidas de investigación, desarrollo y lucha contra las enfermedades que producen.
Este artículo fue publicado originalmente en The Conversation.
Antonio G. Pisabarro es Catedrático de Microbiología, Departamento de Ciencias de la Salud, Instituto de Investigación Multidisciplinar en Biología Aplicada, Universidad Pública de Navarra. Denisse Patricia Rivera de la Torre es Docente en Salud Pública y Epidemiología en la Universidad de Sonora, Universidad de Sonora.
Esta funcionalidad es sólo para suscriptores
Suscribete

Esta funcionalidad es sólo para registrados
Iniciar sesiónEsta funcionalidad es sólo para suscriptores
Suscribete